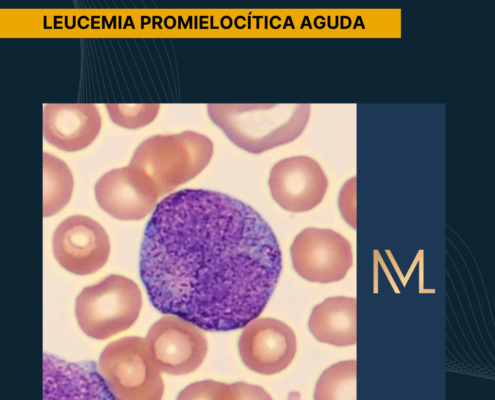
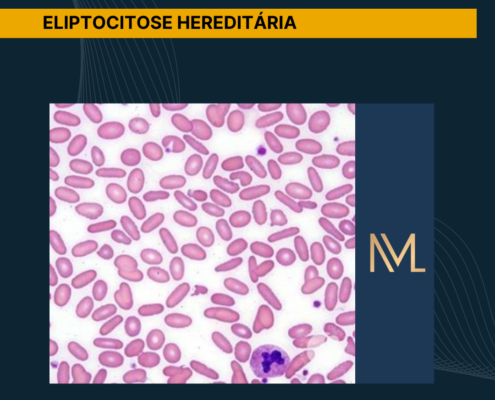

Marcadores hepáticos no uso excessivo de álcool
O consumo de álcool é amplamente disseminado na sociedade atual, sendo considerado um dos principais fatores de risco para diversos problemas de saúde pública. Nesse contexto, o uso excessivo dessa substância está diretamente relacionado…
Leucemia Promielocítica Aguda
A leucemia é uma doença caracterizada pela produção desordenada de células hematopoiéticas, o que compromete a formação normal de hemácias, leucócitos e plaquetas. Como consequência, surgem manifestações como anemia, infecções…

Como a picada de animais peçonhentos pode afetar as plaquetas
Acidentes com animais peçonhentos representam um importante problema de saúde pública em diversas regiões do mundo. A inoculação da peçonha durante a picada desencadeia uma série de reações no organismo humano, envolvendo processos…
Eliptocitose hereditária
A eliptocitose hereditária é um distúrbio hematológico caracterizado por alterações estruturais na membrana dos eritrócitos. Essas alterações ocorrem devido a defeitos em proteínas responsáveis pela estabilidade da célula, o que…

Alterações laboratoriais na Diabetes Mellitus
A Diabetes Mellitus é um grupo de distúrbios metabólicos caracterizados principalmente pela presença de hiperglicemia, resultante de alterações na produção ou na ação da insulina. Essa condição provoca mudanças importantes no metabolismo…

Infecção urinária na gravidez
A infecção do trato urinário (ITU) é uma das doenças infecciosas mais frequentes durante a gestação, podendo acometer entre 5% e 10% das gestantes. Esse quadro pode ocorrer de forma sintomática ou assintomática e está relacionado…

Alterações laboratoriais na psoríase
A psoríase é uma doença inflamatória crônica que, além das manifestações cutâneas, apresenta repercussões sistêmicas relevantes. Nesse contexto, exames laboratoriais podem revelar alterações que refletem a atividade inflamatória…

Alterações hematológicas em pacientes oncológicos
O câncer é um processo patológico caracterizado pela divisão anormal e reprodução celular, com capacidade de invasão e disseminação para tecidos normais. Nesse cenário, pacientes oncológicos estão expostos a importantes alterações…

Alterações laboratoriais na Insuficiência Cardíaca
A insuficiência cardíaca é uma síndrome clínica complexa caracterizada pela incapacidade do coração de suprir adequadamente as demandas metabólicas do organismo. Nesse contexto, os exames laboratoriais assumem papel fundamental, pois…

Interferências do Exercício Físico Intenso nos Exames Laboratoriais
A prática regular de atividade física é amplamente reconhecida como um pilar essencial para a promoção da saúde, contribuindo tanto para o equilíbrio físico quanto para o bem-estar mental. Paralelamente, a realização de exames laboratoriais…
